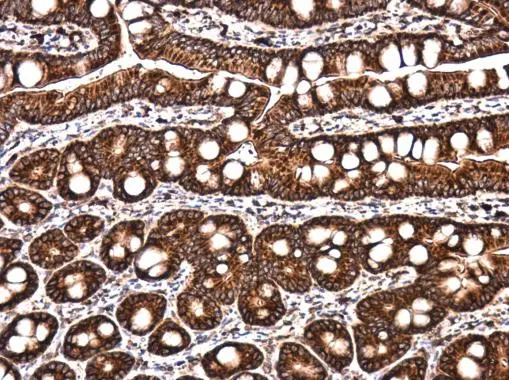
LYRIC antibody detects LYRIC protein at cytoplasm in rat intestine by immunohistochemical analysis. Sample: Paraffin-embedded rat intestine. LYRIC antibody (GTX130679) diluted at 1:500. 
 Antigen Retrieval: Citrate buffer, pH 6.0, 15 min

Various whole cell extracts (30 μg) were separated by 7.5% SDS-PAGE, and the membrane was blotted with LYRIC antibody (GTX130679) diluted at 1:1000.
LYRIC antibody
GTX130679
ApplicationsImmunoFluorescence, Western Blot, ImmunoCytoChemistry, ImmunoHistoChemistry, ImmunoHistoChemistry Paraffin
Product group Antibodies
ReactivityHuman, Rat
TargetMTDH
Overview
- SupplierGeneTex
- Product NameLYRIC antibody
- Delivery Days Customer9
- Application Supplier NoteWB: 1:500-1:3000. ICC/IF: 1:100-1:1000. IHC-P: 1:100-1:1000. *Optimal dilutions/concentrations should be determined by the researcher.Not tested in other applications.
- ApplicationsImmunoFluorescence, Western Blot, ImmunoCytoChemistry, ImmunoHistoChemistry, ImmunoHistoChemistry Paraffin
- CertificationResearch Use Only
- ClonalityPolyclonal
- Concentration0.16 mg/ml
- ConjugateUnconjugated
- Gene ID92140
- Target nameMTDH
- Target descriptionmetadherin
- Target synonyms3D3, AEG-1, AEG1, LYRIC, LYRIC/3D3, protein LYRIC, 3D3/LYRIC, astrocyte elevated gene 1, astrocyte elevated gene-1 protein, lysine-rich CEACAM1 co-isolated protein, metastasis adhesion protein
- HostRabbit
- IsotypeIgG
- Protein IDQ86UE4
- Protein NameProtein LYRIC
- Scientific DescriptionDownregulates SLC1A2/EAAT2 promoter activity when expressed ectopically. Activates the nuclear factor kappa-B (NF-kappa-B) transcription factor. Promotes anchorage-independent growth of immortalized melanocytes and astrocytes which is a key component in tumor cell expansion. Promotes lung metastasis and also has an effect on bone and brain metastasis, possibly by enhancing the seeding of tumor cells to the target organ endothelium. Induces chemoresistance.
- ReactivityHuman, Rat
- Storage Instruction-20°C or -80°C,2°C to 8°C
- UNSPSC41116161

![LYRIC antibody [N2C3] detects LYRIC protein at cytoplasm and nucleus by immunofluorescent analysis. Sample: A431 cells were fixed in 4% paraformaldehyde/PBS for 15 min. Green: LYRIC protein stained by LYRIC antibody [N2C3] (GTX100587) diluted at 1:500. Blue: Hoechst 33342 staining.](https://www.genetex.com/upload/website/prouct_img/normal/GTX100587/GTX100587_41045_IFA_w_23060100_229.webp)
![FACS analysis of HeLa cells using GTX83259 LYRIC antibody [2F11C3]. Green : LYRIC Purple : negative control](https://www.genetex.com/upload/website/prouct_img/normal/GTX83259/GTX83259_20170912_FACS_w_23061322_412.webp)